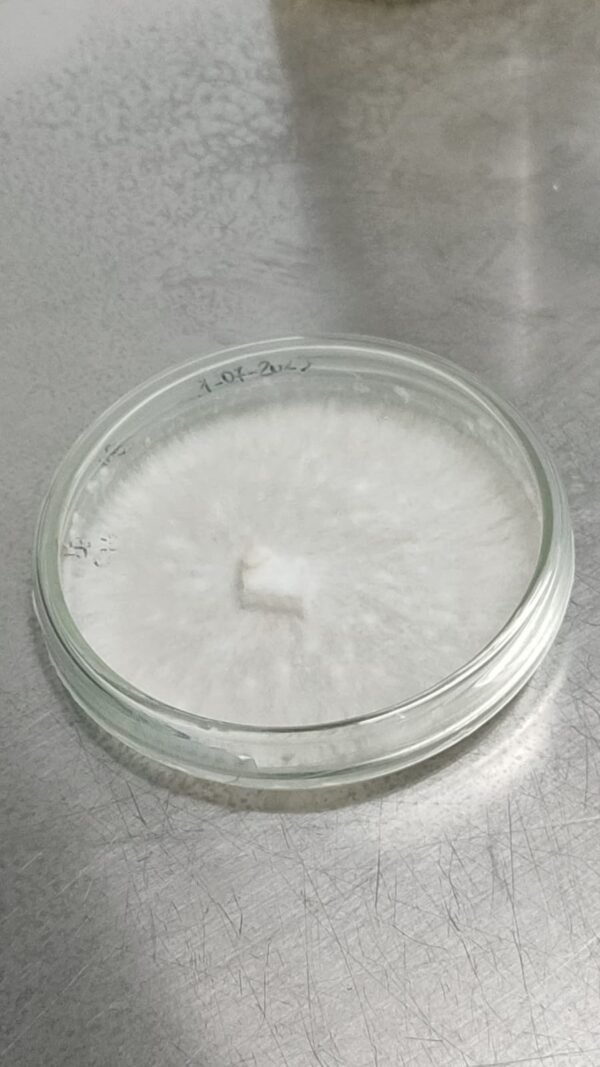
Cultura Pura | Várias Espécies

Cultura Pura em placa Petri
As Placas de Petri com fungos isolados oferecem culturas puras, estáveis e livres de contaminações, ideais para qualquer trabalho de micologia.
- Cada placa é preparada em meio sólido estéril e contém um isolado de primeira geração, garantindo vigor, rapidez de crescimento e excelente uniformidade.
- Cada unidade é enviada devidamente selada e protegida, preservando a frescura e viabilidade do isolado durante o transporte.
- As Placas representam um ponto de partida confiável para qualquer projeto, oferecendo qualidade consistente, facilidade de utilização e resultados previsíveis. Basta abrir, trabalhar em ambiente limpo e iniciar o cultivo.
Indicado para
- expansão para grãos,
- transferência para novas placas,
- pesquisas laboratoriais,
- desenvolvimento de culturas matrizes
- trabalhos de micologia em ambiente profissional ou doméstico.
Utilização
-
Abrir em ambiente limpo e controlado.
-
Transferir o isolado para o meio desejado.
-
Usar em expansão para grão, novas placas ou cultura matriz.
-
Manter as boas práticas de assepsia durante o manuseamento.
Entrega e apoio
- Envio rápido e seguro.
- Tempo de entrega estimado: 2 semanas
- Apoio pós-venda disponível (+351 923 332 993)

Avaliações
Ainda não existem avaliações.